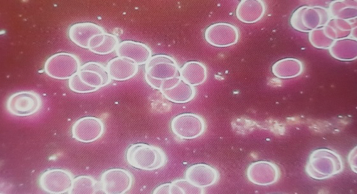

H₂ GENERATOR
The only one of its kind in the world with two membranes
Innovation and technology inspired by nature
Patented membrane technology that enables the production of hydrogen at concentrations of up to
5 ml.
Monoatomic water structure for improved cellular absorption
Original device with a U.S. patent (6022479)
Exclusively available at Eilionoir Graböv


Benefits and Effects
-
Why You Should Drink Hydrogen-Enriched Water?
- Boots energy, vitality and overall well-being
- Slows down the aging process
- Hydrates and oxygenates the body
- Supports detoxification and cellular rejuvenation
- Strengthens the immune system
- Provides Antioxidans effects
- Rejuvenates the skin

-
Scientifically Proben Benefits
- H2 as a powerful antioxidant: neutralizes harmful free radicals
- Regenerates stem cells
- Extends the lenght enzyme-telomerase, significantly extending the lifespan of the human body and maintaining a youthful appearance
- Supports cellular metabolism: reduces oxidative stress
- Optimizes the body´s pH level: balances the acid-alkaline ratio
- Importes blood circulation: reduces blood viscosity

-
Additionally:
- Increased athletic performance
- Support for skin and hair
- DNA stabilization
- Suppression of electromagnetic interference waves (Wi-Fi, cellular communication, television signals)

Health Benefits of Hydrogen-Enriched Water
The strong antioxidant properties of hydrogen-enriched water are especially valuable because we are exposed daily to many sources of free radicals, which cause inflammation. Drinking hydrogen water every day provides antioxidant protection without the need for supplementation.
It slows down the aging process and reduces inflammation.

Water and Longevity
The Japanese have the most extensive experience with hydrogen water therapy and are known for having the highest number of centenarians in the world. They have been drinking hydrogen water for years.
In many places in the world, there are legends about the miraculous effects of water and the associated longevity.
In the mountain village of Kukazu, it was discovered that the local inhabitants are healthy and long-lived due to the special structure and high energetic activity of the water, which is linked to the local geomagnetic field, vibrational frequency, geological composition and other factors.
The activated water obtained recreates a microenvironment that activates frequency information from such water reservoirs and implants, closely resembling the natural geomagnetic field.
Effects have been discovered that go far beyond those of a single type of water, achieved through the combination of two technologies:
- 1. High-hydrogen-content water
2. Low-frequency molekular resonance water (Molecular Resonance Effect Technology)
H2 Generator: Membrane for Optimized Cellular Absorption
The H2 generator not only saturates water with hydrogen but also transforms the water molecule into a monoatomic form that reaches directly into the cell. It features a molecular activation head.
The process occurs without the use of chemical compiunds and the chemical composition of the water remains unchanged after activation. The single-molecule structure of water is crucial for cellular life processes, as it absorbed directly by the cell without requiring the body to convert clustered water into single molecules.
Just 20 minutes after consumption, monoatomic water reduces blood viscosity. This generator produces ionized water with an ORP of up -900 mV to -950 ~ 8 pH, while simultaneously undergoing molecular activation.
Such water awakens the self-healing ability of the cell and starts the repair process of damaged cells.

Water from our device has properties closest to the properties of human cellular water. Drinking water subjected to the molecular resonance process improves the quality of hydration of living cells and has a strong antioxidant effect. It strengthens the body’s immunity and detoxification function.
For athletes, it optimizes performance and results.
For beauty enthusiasts, this water provides true skin protection and rejuvenation – without toxins or side effects.

Scientific basis and research recognized with
a Nobel Prize
In 2003, Dr. Peter Agre received the Nobel Prize
in Chemistry for his discovery of Aquaporin water channels. In his research, Dr. Agre discovered that the body’s cells best absorb water molecules in a single-file structure. The human body normally converts water into the linear structure that cells prefer. However, this process requires energy, and with age, this ability gradually declines, resulting in chronic dehydration.

TECHNOLOGY MOLECULAR RESONANCE EFFECT TECHNOLOGY was patented by Dr. Igor Smirnov , US patent No. 6022479 issued in 2000.
On the left side, you can see clustered water molecules typically found in konventional drinking water.
On the right side, the molecules are arranged in a linear structure that is more easily absorbed by
the body and delivered directly to the cells.
This water not only „penetrates” the body, but also directly nourishes the cells – which may also reduce
the feeling of hunger.
After the molecular resonance activation process, water molecules are rearranged and show a linear structure. Therefore:
The viscosity of water is reduced by 400 times
The absorption efficiency of human cells is increased 300 times
The slipperiness of the water improves by 300 times
BLOOD DROP TEST

Before drinking activated water
20 minutes after drinking water
Test Summary:
After Drinking Low Frequency Resonance Activated Water 20 minutes later, blood viscosity improved significantly.
The test proved that activated water can quickly enter human cells and add energy to cells.
What do you gain by drinking
this water daily?
- Monoatomic water structure – penetrates directly into the cells, providing cellular hydration (for the whole body and skin). Prevents cellular dehydration
- Daily detoxification and improved nutrient transport – vitality and youthfulness
- Daily antioxidant protection – rejuvenation of the entire body
- Strengthening genetic stability of DNA and blocking the production of malignant cells

-

-

Health benefits of hydrogen-enriched water:
- Reduces inflammation and supports the immune system
- Supports nerve conduction and improves blood circulation
- Enhances brain function, relieves stress and anxiety
- Accelerates glucose metabolism, stabilizes blood sugar levels and supports fat burning
- Protects and repairs DNA – reduces the risk of malignant cells
- Supports sport performance – optimizes efficiency and recovery
- Strengthens the skin barrier and aids wound healing
THE REVOLUTION STARTS NOW!
H2 Generator – innovation for optimal hydration, cell protection and improved health
The latest technology that slows down the aging process. Increases energy, vitality and well-being!
-

At the heart of this revolution is hydrogen
-

Technology harmonized with nature
-

An investment in your health and longevity!

Redefine your well-being and vitality:
Available in Desert Gold color, for producing hydrogen water from Eilionoir Graböv – style and health in one!
Our breakthrough technology transforms water into an elixir of youth and well-being.
By combining pure hydrogen with a monoatomic water structure, it penetrates deeper into the cells, providing natural hydration, increased performance, faster recovery and full energy.
Buy now and take the first step towards a healthier, more energetic life!
KNOW MORE ABOUT THE PRODUCT Why choose Eilionoir Graböv´s
H2 Generator?
-
Unique Technology Of Monoatomic Water Structure
This generator is the only generator in the world equipped with a patented membrane that produces a monoatomic water structure.
- Patented technology of molecular resonance effect – developed by Dr. Igor Smirnov, US patent No. 6022479 (2000).
- Hydrogen water has a negative electrical potential of about -200 microvolts – unlike ordinary mineral water, which is positively charged. Supports the body’s energy balance.
-
SPE Technology – Very High Hydrogen Concentration
- The hydrogen generator uses SPE technology, which involves the production and dissolution of hydrogen in the nanohydrogen storage mode. Thanks to this, the hydrogen content can reach up to 5000 ppB (5 ml) – i.e. 10 to 20 times more than in conventional bottles with a high hydrogen content. The higher the hydrogen concentration, the greater the impact on the body.
- To measure the hydrogen concentration, we use a reagent for measuring the concentration of dissolved water imported from Japan. During the measurement, conventional hydrogen bottles release about 2-5 drops, while our device reaches 50 drops.
Highest hydrogen purity 99.9%
- Thanks to the international hydrogen production technology SPE, the purity of the hydrogen produced is 99.9%. The generator works stably, safely and continuously. It is easy to use – hydrogen production begins with the addition of clean water.
- Removal of ozone, residual chlorine and other by-products formed during electrolysis.
- Our H₂ generator reliably removes these residues and guarantees the highest purity.
High ORP (oxidation-reduction potential): -900 to -950.
Two options for hydrogen introduction; by drinking water and inhalation.
-
Design & Durability
- Elegant, lightweight design. The device is perfect for travel – you can enjoy hydrogen-infused water anytime, anywhere.
- Portable and environmentally friendly: No consumables.
- Durable – service life of over 5 years.
- Electrode: 7 layers of platinum coating.
- BPA-free.
-
Therapeutic Potential of Molecular Hydrogen (H₂)
- H₂ is the most powerful antioxidant that protects against hydroxyl radicals and supports the production of glutathione, catalase and other antioxidants in the body.
- Protection against disease and aging with antioxidant and anti-inflammatory properties.
- Safe and non-explosive – hydrogen is characterized by high permeability and diffusion rate. It is recommended to drink water within 10 minutes of the end of hydrogen production.
- Hydrogen can be absorbed at any time of the day. It is recommended to drink 8 glasses a day, between meals (when drinking for the first time, please drink gradually increasing the amount according to individual predispositions). Basically, the more the better.
Fast absorption in the body
- 30 Seconds: Absorbed into the blood.
- 1 Minute: to the brain and genitals.
- 10 minutes: to the skin.
- 20 Minutes: to the liver, heart and kidneys.
-
Product Specifications
- Portable ultra- nano cup 7.8 Hz quantum molecular hydrogen.
- Water capacity: 250 ml.
- Charging voltage: 5 V / Charging current: 1 A (USB-C, waterproof).
- Product Electrode: 7 Layers of Platinum Plating.
- Maximum hydrogen concentration: 5 ppm.
- Charging time: 180 minutes / Hydrogen generator operating time: 60 minutes – 72 minutes.
- Working time: 6 minutes for daily use / 20 minutes for hydrogen inhalation.
-
Important Instructions
- It is strictly forbidden to turn on the device without water. Working without water will damage the electrodes and the membrane.
- Keep the membrane moist: Prevent damage and maintain efficiency.
- Use only clean water: Do not activate any other liquids in the device.
- Do not clean mechanically: Gentle cleaning with citric acid. No dishwasher or aggressive cleaning agents – to ensure longevity, care should be taken gently.
- Use water at room temperature or no higher than 30 degrees C for activation. High water temperatures accelerate the aging of the device.
- The activator can activate all food products containing water in their composition such as; milk, fruit juice, wine, oils, soups, yoghurts, etc. This process can be done in a separate container by repositioning the head. Not in this bottle! In the bottle, limit yourself to clean water only.
- When charging the battery, do not produce hydrogen. Wait until the battery is fully charged.
- A dry aftertaste in the mouth after drinking is quite normal and very positive. This is the effect of activated water penetrating the cells already in the mouth. As a result, you can observe less frequent urination and less frequent eating, because the cells are hydrated.
-
Easy To Use
- Fill the bottle with filtered or bottled water.
- Activate the hydrogen production cycle and select your desired frequency program using the control panel.
- Enjoy the refreshing taste of enhanced water that supports your body, mind, and overall well-being.
-
What’s Included
- Hydrogen bottle: Volume: 250 ml. Dimensions: Diameter 5.5 cm / 21 cm.
- Wireless Charging Pad & USB Charging Cable for convenience on the go.
- Inhalation kit: rubber hose, rubber seal, tube element for fixing.
- Cosmetic bottle with pump – for cream.
- Online User Guide in English for easy setup and maintenance.
-
Ordering, Delivery & Guarantees
- Order Today: We aim to dispatch your order within 2 business days.
- Shipping: Enjoy fast delivery with trusted couriers. You’ll receive a unique tracking link via email, with most shipments arriving within 1–7 days worldwide.
- Secure Payments: Enjoy safe online transactions with a variety of options – including debit and credit cards (Visa, Mastercard).
- Warranty: Every H2 Hydrogen Water Bottle comes with a comprehensive 1-year warranty.





